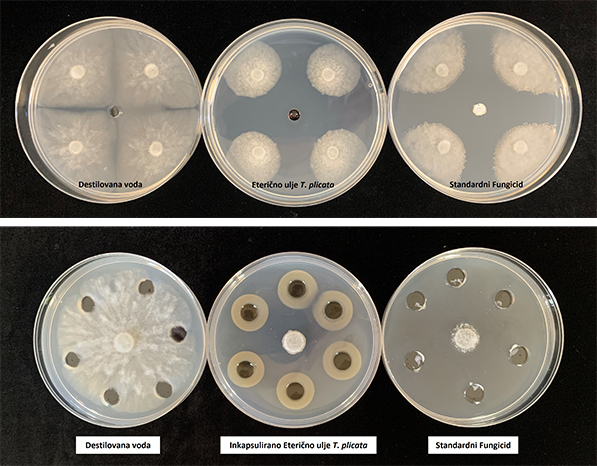
ZAŠTITA BILJA

ZAŠTITA BILJA
Dubravka Marić
Nova generacija biopesticida protiv drvoubica
Protiv spirale nestajanja
Čovek ugrožava šume ne samo kada im namerno nanosi štetu neplanskom sečom i spaljivanjem već i onda kada ih prska hemijskim sredstvima u pokušaju da ih zaštiti od njihovih prirodnih neprijatelja.

Nekroza korena bukve |
U Evropskoj uniji bi, do 2030, upotreba hemijskih pesticida trebalo da bude smanjena za pedeset procenata u odnosu na period od pre juna 2022. godine, kada je Evropska komisija postavila ovakav cilj. U borbi protiv gubara trenutno se koriste samo neki hemijski pesticidi koji su, pri tom, nedovoljno efikasni. Za suzbijanje Phytophthora vrsta u prirodnim šumama nema registrovanih delotvornih pesticida (hemijski ili biološki) pa je osnovna mera zaštite, u stvari, prevencija (izbegavanje unošenja u nezaražena područja). Da bi se postiglo ovako veliko smanjenje korišćenja hemijskih pesticida, potrebno je osmisliti nove strategije zaštite bilja od štetočina.
„Biljke su tokom evolucije razvile višestruke mehanizme zaštite od štetočina i bolesti. Da bi unapredili postojeće metode borbe, naučnici treba da posmatraju i imitiraju prirodu kako bi postojeće prirodne mehanizme uključili u zaštitu biljaka od štetočina i patogena - primenom prirodnih proizvoda. Osnovni problem je nestabilnost tih prirodnih proizvoda, kao što su eterična ulja i biljni ekstrakti, na atmosferskim uslovima. Rešenje koje će zaštititi životnu sredinu od štetočina i sprečiti zagađenje zemljišta, vode i vazduha, zasnovano je na našem novijem patentu, koji je prvobitno razvijen za aktivno pakovanje (produžava rok trajanja svežem voću i povrću zbog svojih antimikrobnih i antioksidativnih svojstava). Rešenje je zasnovano na nanoinkapsulaciji aktivnih komponenti (eteričnih ulja i biljnih ekstrakata) u biopolimernu matricu, i njihovom sporom otpuštanju. Taj isti mehanizam se može primeniti i za biopesticide, gde će se aktivne komponente sporo oslobađati tokom značajnog vremenskog perioda u trajanju od deset dana do nekoliko nedelja. Time se postiže da eterična ulja i biljni ekstrakti imaju produženo dejstvo i da su zaštićeni od uticaja atmosferskih uslova. Projekat ‚PestFreeTree‘, koji je zasnovan na primeni aktivnih supstanci u vidu eteričnih ulja i biljnih ekstrakata, ima za cilj razvoj dva preparata: biopesticida za zaštitu od gubara, i biopesticida za zaštitu od patogena iz roda Phytophthora koji uništavaju koren i druge organe biljaka. Rezultati koje smo postigli u saradnji sa Šumarskim fakultetom Univerziteta u Beogradu i Institutom za proučavanje lekovitog bilja ‚Dr Josif Pančić‘, obećavaju. Projekat će imati dugoročni uticaj na tržište biopesticida, šumarstvo, poljoprivredu, životnu sredinu i društvo uopšte“, ocenjuje dr Goran Branković, naučni savetnik u Institutu za multidisciplinarna istraživanja Univerziteta u Beogradu, i rukovodilac projekta „Novi biopesticidi na principu nanoinkapsulacije i sporog otpuštanja aktivnih komponenti za suzbijanje gubara (Lymantria dispar) i patogena korena u šumama i rasadnicima.“
Projekat se realizuje u okviru „Zelenog programa saradnje nauke i privrede“ Fonda za nauku Republike Srbije, od maja 2023. do maja 2025. uz mogućnost produženja za još godinu dana, ako se za rezultate zainteresuju neki privredni subjekti.

Nekroza kore bukve |
Hrast na jelovniku
Već u prethodnim ispitivanjima, pokazalo se da određene emulzije i eterična ulja deluju antioksidativno i antimikrobno, i uspešno su primenjena na krompirovom moljcu i plamenjači, a odbijala su i puževe golaće. U želji da svoja nova saznanja primene i na šumama, istraživači su, u saradnji sa svojim kolegama sa Šumarskog fakulteta, kao sledeći cilj odabrali gubara i Phytophthora vrste. Gubar je insekt-štetočina koji uništava lišće šumskog drveća i voćki u umerenom pojasu, a široj javnosti je poznat kao neprijatelj hrasta, koji mu je i glavni deo jelovnika. Organizmi iz roda Phytophthora su pseudogljive koje napadaju korenje drvenastih vrsta šireći se na ostale organe biljke. Phytophthora vrste su laicima mnogo poznatije pod nazivom plamenjača ili gljivična bolest koja pogađa krompir (izaziva je Phytophthora infestans koja je dovela do velike gladi u Irskoj, sredinom 19. veka). Gubar može da pojede doslovno svaki list na drvetu, a Phytophthora vrste da „sliste“ i do sto odsto biljnih vrsta na nekom području.
„Gubar se periodično javlja u prenamnoženjima koja nazivamo gradacijama, a kojih je kod nas od šezdesetih godina 19. veka do 2015. bilo dvadeset. I pošto gradacije traju tri do četiri godine, to znači da gubar jednu šumu može da obrsti jednom-dva puta, a ponekad i tri puta, i to u potunosti. To je veliki šok za drveće i ono fiziološki slabi, postaje podložno drugim štetočinama i bolestima od kojih bi inače moglo da se odbrani. Usled toga dolazi do sušenja pojedinačnih stabala ili grupa stabala, gubljenja prirasta, neredovnog plodonošenja. Ne možete da planirate obnavljanje šuma, jer nema žira. Kad gubar obrsti stablo, ono će ponovo olistati, ali će pri tom koristiti rezervne materije, koje onda ne može da iskoristi za formiranje žira, koji mu služi za prirodno obnavljanje. Time se prilično remete ti prirodni procesi. Štete koje gubar pravi nisu samo u gubitku drveta. Ima i puno ekološke štete jer se narušavaju prirodni ciklusi i prirodni odnosi koji postoje u tim veoma kompleksnim šumskim zajednicama. Nevolja je u tome što je on polifagna vrsta. To znači da, kada je u prenamnoženju, može da se hrani na preko 500 vrsta drveća u svetu. Kod nas je registrovano preko 190 takvih vrsta drveća i žbunja. Vrlo često stradaju voćke - bukvalno sve što je zeleno. Phytophthora vrste su patogeni koji pre svega napadaju korenov sistem, ali se posle razaranja korena i drugih tkiva biljke negativne posledice mogu reflektovati i na krunu. Mi smo istraživanjima utvrdili da lišće hrasta postaje pogodnije za ishranu gusenica gubara nakon napada Phytophthora vrstama usled promene hemijskog sastava. Tu imate jednu spiralu smrti, jer takvo stablo postaje podložno napadu drugih štetočina i bolesti“, objašnjava dr Slobodan Milanović, redovni profesor na Katedri zaštite šuma, Šumarskog fakulteta Univerziteta u Beogradu.

levo: Propadanje hrasta luznjaka / desno:Trulež i nekroze korena hrasta |
Raditi sa prirodnim preparatima
Naravno, sve to mnogo košta, pa profesor Milanović podseća na činjenicu da je 1997. u Srbiji bili napadnuto 450 hiljada hektara gubarom i da je vršeno aviotretiranje 250 hiljada hektara biološkim preparatom na bazi bakterije Bacillus thuringiensis var. kurstaki u vrednosti od tadašnjih osam miliona maraka. „PestFreeTree“ rešava sve pomenute probleme kroz razvoj novih, prirodnih i ekološki prihvatljivih biopesticida, koji se mogu primeniti u šumama, parkovima, rasadnicima i voćnjacima.

Nekroza kore javora |
„Naš inovativni koncept je rešenje kojim ćemo zaštititi šumu od nepoželjnih štetočina i ujedno od zagađenja zemljišta, vode i vazduha. Sve aktivne komponente biće eterična ulja i biljni ekstrakti koji pokazuju repelentne, antifidne ili antimikrobijalne efekte na ciljane štetočine. Iako se eterična ulja već koriste za suzbijanje štetočina, njihov glavni nedostatak je kratkoročni efekat, koji je posledica njihove isparljivosti i nestabilnosti u uslovima na otvorenom terenu. Hteo bih i da istaknem da je teško raditi sa prirodnim preparatima. Zašto? Ista ulja kupljena od različitih proizvođača neće delovati na isti način, a čak i ako sledeće godine eterično ulje kupite od istog proizvođača, ono neće biti isto. Upravo zato je važno pažljivo raditi sa njima. U prvim eksperimentima smo probali da radimo sa kupljenim ekstraktom jasena iz Amerike, pošto drugih takvih i nema u prodaji. Onda smo zaključili, da zbog pouzdanosti i ponovljivosti rezultata, moramo sami da ekstraktujemo sva ulja i ekstrakte. Zbog toga je u projekat uključen i Institut ‚Dr Josif Pančić‘. Sa ekstraktom belog i crnog jasena, i kiselog drveta, koji su pripremile kolege sa Instituta ‚Dr Josif Pančić‘, dobili smo izuzetno dobre rezultate. Mislim da zbog teškoća u radu sa prirodnim preparatima, u praksi još uvek nemamo dovoljno biopesticida“, ukazuje prof. dr Goran Branković.
Prva faza laboratorijskih istraživanja je završena, a u junu počinju terenska ispitivanja. Biće to biorazgradivi pesticidi, koji su u potpunosti napravljeni od prirodnih i ekoloških sirovina. Za biopolimernu matricu, koja služi kao nosač aktivnih materija, odabrani su hitozan (hemijski obrađen oblik hitina od koga je napravljen oklop ljuskara) i želatin, jer su to ekološki i prirodni materijali, koji su lako dostupni i međusobno su kompatibilni. U nove formulacije biopesticida su ušli biljni ekstrakti i etarska ulja, koja su u literaturi već bila poznata po efikasnosti, kada je reč o tretiranju određenih vrsta štetočina. Crni i beli jasen su veoma delotvorni u suzbijanju gubara, baš kao i etarska ulja linalola, a čempres, tuja i kleka snažno utiču na Phytophthora vrste. Istraživači ističu i da je veoma važno da novi preparati uopšte nisu toksični.
„Na Phytophthora vrste ovi naši biopesticidi deluju fungistatično, zaustavljajući rast njihovih kolonija pri veoma niskim koncentracijama. Kada je u pitanju gubar, mi smo imali određene kriterijume za selekciju biljnih ekstrakata i esencijalnih ulja, a to je da sredstva koja odaberemo ne smeju imati kontaktnu toksičnost, ili da ona bude minimalna, kako ne bismo ugrozili druge članove šumskog ekosistema, ali i organizme u akvatičnim ekosistemima, zemljištu itd. Druga bitna stvar je da digestivna toksičnost može da se toleriše, ali je povoljnije ako je nema. Ovi ekstrakti kiselog drveta, crnog i belog jasena deluju antifidno na gusenice gubara, kome se ukus lišća više ne dopada. Glavno je da postoji veoma izraženo antifidno i repelentno dejstvo na gusenice gubara čime se sprečavaju velike štete usled defolijacije. Time će šuma sebi ‚kupiti‘ neko vreme, koje će potom iskoristiti prirodni neprijatelji svih tih štetnih organizama, a njih je baš mnogo. I tako će priroda na kraju sama regulisati brojnost štetočina i svesti ih na podnošljiv nivo, gde nemamo velike štete“, zaključuje prof. dr Slobodan Milanović.
Uticaj inkapsuliranog ulja na Phytophthora plurivora |
Dubravka Marić
Kompletni tekstove sa slikama i prilozima potražite u magazinu
"PLANETA" - štampano izdanje ili u ON LINE prodaji Elektronskog izdanja
"Novinarnica"
|